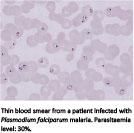

Abstract
Introduction: In this study, we describe patients with imported malaria seen at the Department of Infectious Diseases (DID), Hvidovre Hospital, Denmark. Our aim was to address possible risk factors for contracting malaria and risk factors for developing complicated malaria.
Material and methods: We searched patient databases for all cases of malaria seen at the DID from 1994 to 2012. Various parameters were registered.
Results: A total of 320 cases were identified. We found a significant 3.39 % decrease in the incidence of cases per year (p = 0.0008). Plasmodium falciparum infection was predominant (n = 217) followed by P. vivax infection (n = 76). 37% of all cases were Africans visiting relatives and friends (VRF). A total of 12 patients had one or more relapses of their P. vivax infection. In all, 53 (17%) cases were defined as severe malaria. 36% (n = 112) reported using some type of chemoprophylaxis. 14% (n = 26) of patients traveling to Africa in 1999-2012 reported taking chemoprophylaxis as recommended in the current guidelines. Complicated malaria was significantly associated with failure to take any chemoprophylaxis (p = 0.0317, χ2-test).
Conclusion: Imported malaria is decreasing at the DID. The patients who carry the highest risk of imported malaria are ethnic Africans who travel as VRF without using chemoprophylaxis. Recrudescence from P. vivax malaria is a substantial risk. Complicated malaria is associated with failure to take any chemoprophylaxis. It is important that travelers receive expedient advice on the use of efficient chemoprophylaxis to bring down the number of imported malaria cases.
Funding: not relevant.
Trial registration: not relevant.
Abstract
Introduction: In this study, we describe patients with imported malaria seen at the Department of Infectious Diseases (DID), Hvidovre Hospital, Denmark. Our aim was to address possible risk factors for contracting malaria and risk factors for developing complicated malaria.
Material and methods: We searched patient databases for all cases of malaria seen at the DID from 1994 to 2012. Various parameters were registered.
Results: A total of 320 cases were identified. We found a significant 3.39 % decrease in the incidence of cases per year (p = 0.0008). Plasmodium falciparum infection was predominant (n = 217) followed by P. vivax infection (n = 76). 37% of all cases were Africans visiting relatives and friends (VRF). A total of 12 patients had one or more relapses of their P. vivax infection. In all, 53 (17%) cases were defined as severe malaria. 36% (n = 112) reported using some type of chemoprophylaxis. 14% (n = 26) of patients traveling to Africa in 1999-2012 reported taking chemoprophylaxis as recommended in the current guidelines. Complicated malaria was significantly associated with failure to take any chemoprophylaxis (p = 0.0317, χ2-test).
Conclusion: Imported malaria is decreasing at the DID. The patients who carry the highest risk of imported malaria are ethnic Africans who travel as VRF without using chemoprophylaxis. Recrudescence from P. vivax malaria is a substantial risk. Complicated malaria is associated with failure to take any chemoprophylaxis. It is important that travelers receive expedient advice on the use of efficient chemoprophylaxis to bring down the number of imported malaria cases.
Funding: not relevant.
Trial registration: not relevant.
In Denmark, we have observed a variation in the number of imported malaria cases during the past decade [1]. In this study, we describe patients with imported malaria seen at the Department of Infectious Diseases (DID), Hvidovre Hospital (HVH), Denmark. Our aim was to address possible risk factors for contracting malaria and risk factors for developing complicated malaria. Annual reports of imported malaria in Denmark only describe the number of cases and the country of origin [1]. In this study, we include detailed patient data which allows us to describe risk factors for acquiring malaria among our travelers with imported malaria.
MATERIAL AND METHODS
We searched our patient database for all cases of malaria and double-checked with the microbiological database for all samples that had tested positive by malaria microscopy. We included all patients who were diagnosed or treated for malaria at the DID during the period from January 1994 to December 2012. A diagnosis of malaria was based on microscopy of three thin and three thick blood smears per patient. Patients suspected of malaria had malaria smears performed daily for three consecutive days. Age, gender, country of origin, destination, duration of travel, purpose of travel, chemoprophylaxis, treatment, complications and other parameters were registered. SAS version 9.2 was used for statistical analysis. A professional statistician was consulted. Malaria incidences were estimated as “trend over time” using the Poisson regression (n = 317). Travel length in relation to the use of chemoprophylaxis was estimated using a Mann Whitney-test (n = 249). Complicated malaria in relation to age was estimated using a Mann Whitney-test (n = 318). Complicated malaria in relation to ethnicity was estimated using Fisher’s exact test (n = 309). Complicated malaria in relation to use of chemoprophylaxis was estimated using the χ2-test (n = 300). Doctors’ delays were estimated using odds ratio (n = 316). Complicated malaria in relation to doctors’ delay was estimated using the χ2-test (n = 312).
Trial registration: not relevant.
RESULTS
Origin and types of imported malaria
A total of 320 cases of imported malaria were identified. 57% (n = 183) of the cases were male. The mean age was 34.6 years (range: 1-71 years), Table 1 1.
Plasmodium falciparum infection was predominant (n = 217), followed by P. vivax infection (n = 76), Table 1.
A total of 231 cases were imported from Africa, and 87% of those were P. falciparum infections. In all, 70 cases were imported from Asia, and 16% of those were P. falciparum infections, whereas 83% were P. vivax infections, Table 1.
We found a significant decrease in the total number of cases of 3.39% cases per year (p = 0.0008) during the observed 19-year-period. The decline was due to fewer cases from Asia, with a significant decrease in the number of cases of 6.55% per year (p = 0.0066), Table 2. The number of cases from Africa remained stable; however, in 2000 imported cases from Africa peaked with 28 cases of imported malaria, Figure 1.
Recrudescence and relapses
Three patients had recrudescence of P. falciparum or P. malariae defined by a positive blood smear within 28 days of initial treatment. A total of 12 patients had one or more relapses of their P. vivax infection. One patient had a relapse of a P. ovale infection, Table 1.
Five patients diagnosed with relapse of a P. vivax infection were initially diagnosed with P. falciparum, and thus did not receive treatment with primaquine phosphate. They were later re-diagnosed and treated for P. vivax infection, which indicates either an incorrect initial diagnosis or a missed diagnosis due to an underlying double infection.
Six patients experienced relapse of P. vivax or P. ovale despite having received primaquine phosphate treatment when initially diagnosed. Four contracted their malaria during travels to Asia and two in connection with travels to the Americas. Five patients experienced multiple relapses. All five had traveled to Asia (India, Pakistan, Indonesia and Thailand).
Only two patients, both ethnic Pakistanis, were diagnosed with glucose-6-phosphate-dehydrogenase deficiency.
In all, 12 patients had more than one case of malaria infection, not counting as either recrudescence or relapse. Nine were of Sub-Saharan African ethnicity, and three patients were ethnic Danes, Table 1.
Purpose of travel and ethnicity
The purpose of travel was registered, and 37% of cases were Africans traveling to visit relatives and friends, 23% were Danes traveling as tourists, 10% were Asians traveling to visit relatives and friends, or residents in malaria endemic areas, Table 3. 42% (n = 55) of all Danes either traveled to visit relatives and friends, were on work-related travels or were residents in malaria-endemic areas, and we expected that these groups would have a longer travel duration than tourists. Travel duration in different groups was registered, but data were incomplete, especially for residents. Contrary to our expectations, the travel duration of Danish tourists with malaria exceeded that of Danes and Africans visiting relatives and friends, Table 2. A total of 22 of the 73 Danes reported traveling as backpackers with a mean travel duration of 111 days, which explains the above pattern. Petersen et al demonstrated that long-term travelers were more prone to terminate prophylaxis due to suspected side effects [2]. We found no significant differences between the travel duration of patients reporting taking chemoprophylaxis (mean = 69 days) and patients not taking any chemoprophylaxis (mean = 67 days) (p = 0.0775, Mann Whitney-test).
Chemoprophylaxis
65% (n = 207) did not report use of any chemoprophylaxis. 14% (n = 44) used chloroquine/proguanil, 7% (n = 22) used only chloroquine, 4 % (n = 13) used mefloquine, 3% (n = 9) used atovaquon/proguanil and 2% (n = 6) used Doxycycline. 6% (n = 18) reported use of other or unknown chemoprophylaxis.
A total of 36% (n = 112) reported using chemoprophylaxis, which is low compared with a similar study in which 58% of patients reported taking chemoprophylaxis [3]. 17% (n = 19) of those who reported taking chemoprophylaxis had taken it insufficiently, mainly due to observed adverse effects.
49% (n = 39) of Danes and 20% (n = 30) of Africans traveling to Africa used chemoprophylaxis. During 1999-2012, only 26 of 189 (14%) patients traveling to Africa reported taking a sufficient chemoprophylaxis (mefloquine, Doxcycline and atovaquon/proguanil) as recommended in the current guidelines. 50% (n = 34) of Danes and 0% of Asians traveling to Asia used chemoprophylaxis.
Complicated malaria
Severe malaria is primarily defined by clinical and biochemical assessment of the patient. Thus, parasitaemia alone is a poor predictor of disease severity. The WHO guidelines describe that patients from non-endemic areas or areas with very low malaria transition are considered non-immune to malaria, and they are therefore more prone to progress into severe malaria at a lower parasitaemia level of 2-2.5% [4].
A total of 46 patients with a parasitaemia level of 2-5% were identified. In all, 11 were of Danish ethnicity and one was of Icelandic ethnicity. They were considered non-immune to malaria and thus categorized as severe malaria.
A total of 53 (17%) patients were defined as having severe malaria based on the following criteria (some patients had multiple criteria for severe malaria): a parasitaemia level of 2-5% (n = 12), a parasitaemia level of > 5% (n = 34), pregnancy (n = 7) cerebral affection (n = 8) or kidney failure (n = 3).
No deaths were recorded. However, one of the pregnant patients miscarried, and three patients received exchange blood transfusion, Table 1. Known risk factors for mortality from imported malaria are older age, European origin, failure to take chemoprophylaxis and patients and doctor’s delay in seeking and providing medical care [5, 6].
A 0.5-5% case fatality rate has been reported for imported malaria in Europe [7]. We had no deaths in our observed period. Thus, we assessed risk factors associated with complicated malaria instead. We found that older age was associated with complicated malaria (mean: 38 years versus 34 years), (p = 0.0552. Mann Whitney-test), though with little difference in age; and our results were not statistically significant. This may be explained by the fact that the majority of our complicated malaria cases were categorized on the basis of parasitaemia and not on severity of disease. Complicated malaria was significantly associated with failure to take any chemoprophylaxis (p = 0.0329, χ2-test). We also found a significant difference (p = 0.0134, Fisher’s exact test) in the number of complicated malaria cases between ethnic groups based on the following groups: Denmark, Europe, Asia, Africa and the Americas, with Denmark having the highest prevalence (50%) of complicated malaria.
Doctor’s delay
A total of 52 cases of doctor’s delay were observed (mean: eight days). Hence, the patients who were diagnosed late with malaria had contacted the health system in the days before diagnosis were made. There was a tendency towards fewer cases of doctor’s delay during the observed period (% doctor’s delay/year odds ratio = 0.971; 95% confidence interval: 0.915-1.032), but it did not reach the level of statistical significance (p = 0.082). A total of 11 patients with complicated malaria experienced doctor’s delay (mean = four days), but with no significant association between frequency of complicated malaria and doctor’s delay (p = 0.2931, χ2-test). Information on patient’s delay was not accessible, but may also have contributed to delay of diagnosis.
Treatment
During the first 13 years of the period, oral chloroquine and mefloquine were the choice for treatment of uncomplicated malaria, whereas atovaquon/proguanil was the primary choice during the last six years observed. Experience with the use of atovaquon/proguanil as treatment for P. falciparum malaria has accumulated in Danish hospitals in later years, and is now the first line treatment in most of Denmark in line with artemether/lumefantrine [8, 9]. Oral chloroquine (adding a two-week course of primaquine in vivax and ovale cases) remains the first choice in the treatment of uncomplicated vivax, malariae and ovale malaria. Chloroquine resistance in P. vivax has been reported worldwide, but only sporadically [10, 11].
Intravenous (IV) quinine was used for treatment of complicated malaria during the first 14 years observed. In the last five years observed, IV artesunate combined with oral atovaquon/proguanil has become first choice for treatment of complicated malaria, though quinine remains in use when treating pregnant women.
DISCUSSION
The number of imported malaria cases at the DID decreased during the observed period owing to fewer malaria cases from Asia. This pattern was also reported in the United Kingdom by Smith et al, with a decrease in cases from the Indian subcontinent from 31% in 1987-1991 to 8% in 2002-2006 [12]. The malaria incidence in South Asia declined during this period, but this could not in itself explain the decrease in imported cases [12]. Smith et al hypothesized that travelers visiting family members in the region increasingly stayed in urban settings where local control measures have been most effective in reducing local transmission of malaria [12].
Imported cases from Africa remained stable in contrast to reports from Statens Serum Institut (SSI). Thus, the SSI reported a decline in imported cases from Africa to Denmark during the 2001-2012 period. We observed a peak incidence in 2000, which also appeared in reports from the SSI [1]. Kofoed & Petersen also reported a peak of imported malaria from Africa in 2000 and stated that this might be due to an increase in the number of travels to Africa (based on data from World Tourism Organization) and to an increase in chloroquine and proguanil-resistant P. falciparum, which was the prophylaxis of choice in Africa until 1999. Also, they stated that new recommendations on chemoprophylaxis in 1999 (atovaquon/proguanil, mefloquine or Doxycycline) did not reach travelers until years later [7].
We found a relapse rate of 16% in patients with P. vivax infection, Table 1. 6.5% experienced relapse despite adding primaquine treatment. The above relapse rate was expected when comparing reported relapse rates in the literature. Pukrittayakamee et al reported a 50% relapse rate in patients with P. vivax treated with chloroquine monotherapy and an approximately 20% relapse rate in patients treated with both chloroquine and primaquine [11].
Patient’s delay and doctor’s delay are well described risk factors for mortality in imported malaria [13]. We found no significant association between doctor’s delay and complicated malaria, but our mean of eight days was consistent with other reports of 4-8.5 days of delay from symptom onset to treatment [5], which indicates that doctor’s delay in Denmark is not markedly different from the delay in other countries with imported malaria.
Atovaquon/proguanil was initially marketed in Denmark in July 1998, and data on prescription sales from the SSI show a marked increase in the daily defined dose from 1998 to 2012 [14]. Atovaquon/proguanil has markedly fewer side-effects than mefloquine, for instance, and a shorter post-travel regimen than doxycycline, which prompts better compliance in travelers [6]. It is likely that part of the observed national decrease in imported malaria from 2001 to 2012 is associated with the increasing use of atovaquon/proguanil as chemoprophylaxis. In contrast, the lack of use of any chemoprophylaxis or the use of insufficient chemoprophylaxis may explain why imported cases from Africa remained stable at the DID during the observed period. The use of chemoprophylaxis was low in ethnic Africans and Asians compared with the use in Danes. Cultural differences may influence on the incentive to seek pre-travel medical advice. Similarly, having the economic means for acquiring prophylaxis for an entire family may differ among travelers of different ethnicity.
CONCLUSION
Imported malaria from Africa remains stable, while imported malaria from Asia is decreasing at the DID. Africans visiting relatives and friends incur the greatest risk of contracting imported malaria. Relapse from P. vivax malaria is a substantial risk despite relevant treatment. Complicated malaria is associated with failure to take any chemoprophylaxis. It is important that travelers receive correct advice and that they are encouraged to use efficient chemoprophylaxis; these measures may assist efforts to bring down the number of imported malaria cases.
Correspondence: Camilla Holten Møller, Adilsvej 9, 2., 2000 Frederiksberg, Denmark. E-mail: cholt25@hotmail.com
Accepted: 19 February, 2014
Conflicts of interest:Disclosure forms provided by the authors are available with the full text of this article at www.danmedj.dk

REFERENCES
EPI-NEWS no. 24, 2010 and no. 19/20, 2002. www.ssi.dk/Aktuelt/Nyhedsbreve/EPI-NYT.aspx (17 Dec 2013).
Petersen E, Rønne T, Rønn A et al. Reported side effects to Chloroquine plus Proguanil, and Mefloquine as chemoprophylaxis against malaria in Danish travelers. J Travel Med 2000;7:79-84.
Hornstrup MK, Gahrn-Hansen B, Hallas J et al. Imported malaria in the county of Funen, Denmark, 1987-1999. Ugeskr Læger 2002;164:2038-41.
WHO Management of severe malaria, a practical handbook. www.who.int/malaria/publications/atoz/9789241548526/en/ (17 Dec 2013).
Checkley AM, Smith A, Smith V et al. Risk factors for mortality from imported falciparum malaria in the United Kingdom over 20 years: an observational study. BMJ 2012;344:e2116.
Goodyer L, Rice L, Martin A. Choice of and adherence to prophylactic antimalarials. J Travel Med 2011;18:245-9.
Kofoed K, Petersen E. The Efficacy of chemoprophylaxis against malaria with Chloroquine plus Proguanil, Mefloquine, and Atovaquon plus Proguanil in travelers from Denmark. J Travel Med 2003;10:150-4.
Thybo S, Gjorup I, Ronn AM et al. Atovaquone-proguanil (Malarone): an effective treatment for uncomplicated plasmodium falciparum malaria in travelers from Denmark. J. Travel Med 2004;11:220-4.
Danish Society of Infectious Diseases’ Guideline on malaria treatment www.infmed.dk/site/tools/download.php?UID=06ced37c970203bdd3d39368d680247b003d41b2 (17 Dec 2013).
Price RN, Douglas NM, Anstey NM et al. Plasmodium vivax treatments: what are we looking for? Curr Opin Infect Dis 2011;24:578-85.
Pukrittayakamee S, Chantra A, Simpson JA et al. Therapeutic responses to different antimalarial drugs in vivax malaria. Antimicrob Agents Chemother 2000;44:1680-5.
Smith AD, Bradley DJ, Smith V et al. Imported malaria and high risk groups: observational study using UK surveillance data 1987-2006. BMJ 2008;337:a120.
Newman RD, Parise ME, Barber AM et al. Malaria-related deaths among U.S. travelers, 1963-2001. Ann Intern Med 2004;141:547-55.
http://medstat.dk/ (17 Dec 2013).